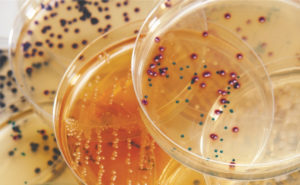
ID Flexicult®

Contact us
Flexicult® is your aid in diagnosis and treatment of urinary tract infections
Flexicult® is a fast and simple culture test designed for diagnosing urinary tract infections (UTI) by:
- identification and quantitative enumeration of bacteria in the urine
- predicts the susceptibility of the bacteria against 5 antibiotics
Flexicult® is designed as an agar plate with elevated sides and divided into compartments with partitions and a lid. There is one large compartment for quantitative analysis and 5 small compartments each containing a specific antibiotic.
UTI products
As Flexicult® is our aid in the diagnosis of UTI we have created more variants to fit as many needs as possible.
- Flexicult® Urinary Kit, for diagnostics of human urinary tract Infections
- Flexicult® Vet, for diagnostics of UTI in dogs or cats
- ID Flexicult® is an agarplate for identification of urinary pathogenic bacteria.
Flexicult® Solutions

Flexicult® Urinary Kit
Flexicult® Urinary Kit is your aid in urinary tract infections. By culturing on Flexicult®Urinary Kit you will get bacteria species, amount of bacteria present and which antibiotic to use.
Fast, easy and reliable.

Flexicult® Vet
Flexicult® Vet is an aid for antibiotic treatment for cats and dogs during Urinary tract infection. Flexicult® indicates bacteria species, amount of bacteria and which antibiotic to use.
ID Flexicult®
Detection of pathogenic bacteria which causes urinary tract infections. Culturing the urinary sample on ID Flexicult® will give you an indication of which bacteria that is present based on the colour and size of the bacteria colony.
Get in touch
If you have any questions, comments, or collaboration inquiries, you are very welcome to reach out.
Please fill in the form and we will get back to you as soon as possible.